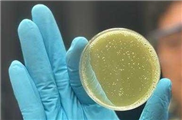

Irgendwann vor mehr als 5000 Jahren kam der Mensch auf die Idee, eine Wunde mit Nadel und Faden zu vernähen. Seither hat sich an diesem chirurgischen Prinzip nicht viel geändert: Abhängig vom Fingerspitzengfühl der operierenden Person und der Ausrüstung lassen sich Schnitte oder Risse im Gewebe mehr oder weniger perfekt aneinanderfügen. Sind dann beide Seiten einer Wunde sauber aufeinander fixiert, kann der Körper beginnen, die Gewebelücke auf natürliche Weise dauerhaft zu schliessen.
Doch nicht immer erreicht die Naht, was sie soll: Bei sehr weichen Geweben kann der Faden durch das Gewebe schneiden und zusätzliche Verletzungen verursachen. Und wenn der Wundverschluss an inneren Organen nicht dichthält, können durchlässige Nähte ein lebensbedrohliches Problem darstellen. Forschende der Empa und der ETH Zürich haben nun einen Weg gefunden, Wunden mittels Laser zu verlöten.

Keramik-Nanopartikel wirken also winzige Thermometer in der «iSolder»-Paste zum Löten von Wunden. Bild: Empa
Temperatur in Echtzeit steuern
Beim Löten werden üblicherweise Werkstoffe mittels Hitze über ein schmelzendes Verbindungsmittel aneinandergefügt. Dass diese thermische Reaktion bei biologischen Materialien in engen Grenzen bleiben muss und gleichzeitig die Temperatur auf nicht-invasive Weise schwierig zu messen ist, war bisher ein Problem für die Anwendung von Lötverfahren in der Medizin. Das Team um Oscar Cipolato und Inge Herrmann vom «Particles Biology Interactions»-Labor der Empa in St. Gallen und dem «Nanoparticle Systems Engineering Laboratory» der ETH Zürich tüftelte daher an einem smarten Wundverschluss-System, bei dem sich das Laser-Löten schonend und effizient steuern lässt. Sie entwickelten hierzu ein Verbindungsmittel mit Metall- und Keramik-Nanopartikeln und setzten ein Nanothermometrie-Verfahren zur Temperaturkontrolle ein.
Die Eleganz des neuen Lötverfahrens beruht dabei auch auf dem Zusammenspiel der zwei Nanopartikel-Arten in der verbindenden Eiweiss-Gelatine-Paste. Während die Paste mittels Laser bestrahlt wird, wandeln Titannitrid-Nanopartikel das Licht in Wärme um. Die eigens synthetisierten Bismutvanadat-Partikel in der Paste wirken hingegen als winzige fluoreszierende Nanothermometer: Sie strahlen temperaturabhängig Licht spezifischer Wellenlänge ab und erlauben so eine äusserst präzise Temperaturregulierung in Echtzeit. Damit ist die Methode besonders geeignet für die Anwendung in der minimal invasiven Chirurgie, da sie ohne Berührung auskommt und Temperaturdifferenzen mit feinster räumlicher Auflösung in oberflächlichen und tiefen Wunden ermittelt.
Schonendes Infrarotlicht
Nachdem das Team die Bedingungen für das «iSoldering» (Englisch für «intelligentes Löten») über mathematische Modellierungen «in silico» optimiert hatte, konnten die Forschenden die Leistungsfähigkeit des Kompositmaterials untersuchen. Gemeinsam mit Chirurgen und Chirurginnen des Universitätsspital Zürich, der «Cleveland Clinic» (USA) und der tschechischen Karls-Universität erzielte das Team in Labortests mit verschiedenen Gewebeproben eine schnelle, stabile und bioverträgliche Verbindung von Wunden beispielsweise an Organen wie der Bauchspeicheldrüse oder der Leber. Ebenso erfolgreich und schonend verlief das Versiegeln von besonders anspruchsvollen Gewebestücken etwa der Harnröhre, des Eileiters oder des Darms mittels iSoldering. Mittlerweile ist das Nanopartikel-Kompositmaterial denn auch zum Patent angemeldet.
Doch damit gaben sich die Forschenden noch nicht zufrieden: Es gelang ihnen, die Laser-Lichtquelle durch schonenderes Infrarotlicht zu ersetzen. Dies bringt die Löttechnologie einen weiteren Schritt näher zur Anwendung im Spital: «Würde mit bereits medizinisch zugelassenen Infrarotlampen gearbeitet, liesse sich die innovative Löttechnik ohne zusätzliche Laser-Schutzmassnahmen in herkömmlichen Operationssälen verwenden», sagt Empa-Forscherin Inge Herrmann.